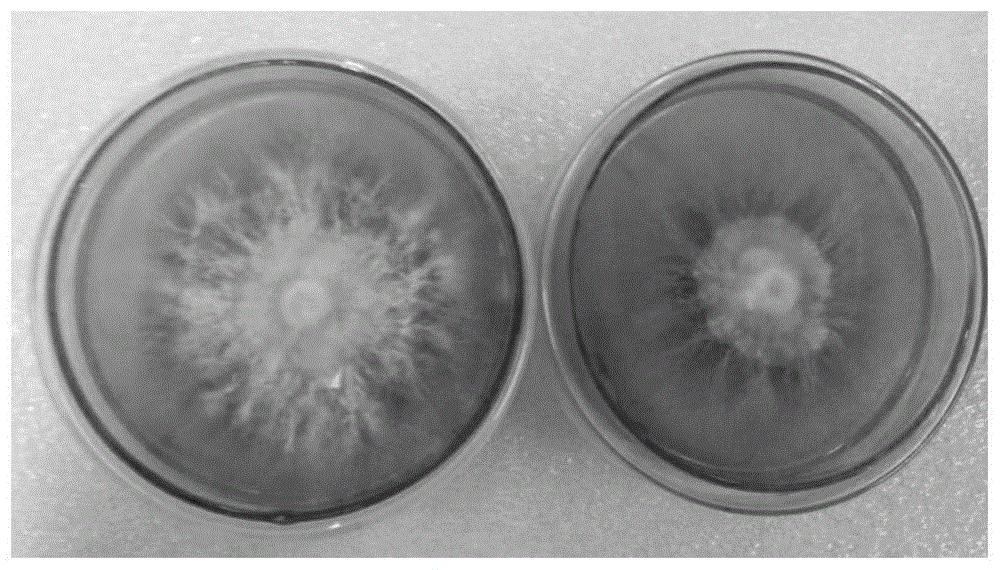
一种恶臭假单胞菌s9及其在促进鸡腿菇生长中的应用

恶臭假单胞菌

假单胞菌属
图片尺寸300x240
假单胞菌(其他生物相关)_技点百科_技点网(其他生物相关)
图片尺寸864x686
恶臭假单胞npp01及其在制备δ-癸内酯中的应用制造技术,恶臭假单胞菌
图片尺寸887x792
pseudomonas putida atcc 49128 恶臭假单胞菌
图片尺寸499x499
一种恶臭假单胞菌s9及其在促进鸡腿菇生长中的应用
图片尺寸1000x570
一株恶臭假单胞菌菌株及其降解烟酸的应用的制作方法
图片尺寸1000x986
假单胞菌属|2|8
图片尺寸352x289
一种恶臭假单胞菌s9及其在促进鸡腿菇生长中的应用的制作方法
图片尺寸1000x570
pseudomonas putida kt2440 恶臭假单胞菌kt2440应激反应的关键因素
图片尺寸800x800
恶臭假单胞菌
图片尺寸268x204
假单胞菌科|2|21
图片尺寸220x218
假单胞菌(pseudomonas)
图片尺寸640x480
一株恶臭假单胞菌x14及其应用方法与流程
图片尺寸1000x733
假单胞菌科
图片尺寸1327x1338
铜绿假单孢菌的的自白书
图片尺寸604x600
假单胞菌科|2|21
图片尺寸180x220
菌铜绿假单胞菌
图片尺寸1200x800
绿脓假单胞菌
图片尺寸220x119
一株转入红色荧光蛋白的恶臭假单胞菌及其应用的制作方法
图片尺寸610x458
一株降解香豆素的恶臭假单胞菌及应用的制作方法
图片尺寸1000x620